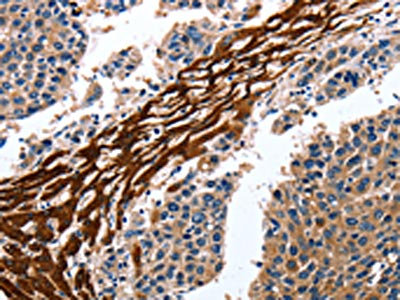

CYP3A4 Antibody
-
中文名稱:CYP3A4兔多克隆抗體
-
貨號:CSB-PA178836
-
規格:¥1100
-
圖片:
-
The image on the left is immunohistochemistry of paraffin-embedded Human liver cancer tissue using CSB-PA178836(CYP3A4 Antibody) at dilution 1/15, on the right is treated with fusion protein. (Original magnification: ×200)
-
Gel: 10%SDS-PAGE, Lysate: 40 μg, Lane: Mouse liver tissue, Primary antibody: CSB-PA178836(CYP3A4 Antibody) at dilution 1/300, Secondary antibody: Goat anti rabbit IgG at 1/8000 dilution, Exposure time: 5 seconds
-
-
其他:
產品詳情
-
Uniprot No.:
-
基因名:CYP3A4
-
別名:CYP3A4; CYP3A3; Cytochrome P450 3A4; 1,4-cineole 2-exo-monooxygenase; 1,8-cineole 2-exo-monooxygenase; Albendazole monooxygenase; sulfoxide-forming; Albendazole sulfoxidase; CYPIIIA3; CYPIIIA4; Cholesterol 25-hydroxylase; Cytochrome P450 3A3; Cytochrome P450 HLp; Cytochrome P450 NF-25; Cytochrome P450-PCN1; Nifedipine oxidase; Quinine 3-monooxygenase
-
宿主:Rabbit
-
反應種屬:Human,Mouse
-
免疫原:Fusion protein of Human CYP3A4
-
免疫原種屬:Homo sapiens (Human)
-
標記方式:Non-conjugated
-
抗體亞型:IgG
-
純化方式:Antigen affinity purification
-
濃度:It differs from different batches. Please contact us to confirm it.
-
保存緩沖液:-20°C, pH7.4 PBS, 0.05% NaN3, 40% Glycerol
-
產品提供形式:Liquid
-
應用范圍:ELISA,WB,IHC
-
推薦稀釋比:
Application Recommended Dilution ELISA 1:1000-1:2000 WB 1:200-1:1000 IHC 1:50-1:200 -
Protocols:
-
儲存條件:Upon receipt, store at -20°C or -80°C. Avoid repeated freeze.
-
貨期:Basically, we can dispatch the products out in 1-3 working days after receiving your orders. Delivery time maybe differs from different purchasing way or location, please kindly consult your local distributors for specific delivery time.
-
用途:For Research Use Only. Not for use in diagnostic or therapeutic procedures.
相關產品
靶點詳情
-
功能:A cytochrome P450 monooxygenase involved in the metabolism of sterols, steroid hormones, retinoids and fatty acids. Mechanistically, uses molecular oxygen inserting one oxygen atom into a substrate, and reducing the second into a water molecule, with two electrons provided by NADPH via cytochrome P450 reductase (NADPH--hemoprotein reductase). Catalyzes the hydroxylation of carbon-hydrogen bonds. Exhibits high catalytic activity for the formation of hydroxyestrogens from estrone (E1) and 17beta-estradiol (E2), namely 2-hydroxy E1 and E2, as well as D-ring hydroxylated E1 and E2 at the C-16 position. Plays a role in the metabolism of androgens, particularly in oxidative deactivation of testosterone. Metabolizes testosterone to less biologically active 2beta- and 6beta-hydroxytestosterones. Contributes to the formation of hydroxycholesterols (oxysterols), particularly A-ring hydroxylated cholesterol at the C-4beta position, and side chain hydroxylated cholesterol at the C-25 position, likely contributing to cholesterol degradation and bile acid biosynthesis. Catalyzes bisallylic hydroxylation of polyunsaturated fatty acids (PUFA). Catalyzes the epoxidation of double bonds of PUFA with a preference for the last double bond. Metabolizes endocannabinoid arachidonoylethanolamide (anandamide) to 8,9-, 11,12-, and 14,15-epoxyeicosatrienoic acid ethanolamides (EpETrE-EAs), potentially modulating endocannabinoid system signaling. Plays a role in the metabolism of retinoids. Displays high catalytic activity for oxidation of all-trans-retinol to all-trans-retinal, a rate-limiting step for the biosynthesis of all-trans-retinoic acid (atRA). Further metabolizes atRA toward 4-hydroxyretinoate and may play a role in hepatic atRA clearance. Responsible for oxidative metabolism of xenobiotics. Acts as a 2-exo-monooxygenase for plant lipid 1,8-cineole (eucalyptol). Metabolizes the majority of the administered drugs. Catalyzes sulfoxidation of the anthelmintics albendazole and fenbendazole. Hydroxylates antimalarial drug quinine. Acts as a 1,4-cineole 2-exo-monooxygenase. Also involved in vitamin D catabolism and calcium homeostasis. Catalyzes the inactivation of the active hormone calcitriol (1-alpha,25-dihydroxyvitamin D(3)).
-
基因功能參考文獻:
- Experimental in silico and in vivo studies confirmed that the original Russian benzodiazepine phenazepam was the substrate of CYP3A4 isoenzyme. PMID: 29727298
- Apigenin showed reversible inhibition, acacetin, and chrysin showed combined irreversible and reversible inhibition while chrysin dimethylether, isorhamnetin, pinocembrin, and tangeretin showed pure irreversible inhibition. These results alert on possible flavonoiddrug interactions on the level of CYP3A4 PMID: 30301254
- This patient should be regarded as a CYP3A-poor metabolizer. PMID: 29469606
- spectroscopic studies clarified the heteroactivation of CYP3A4 caused by efavirenz with a proper affinity to the peripheral site PMID: 29191071
- The genetic polymorphisms of the multi-drug resistance-1 (MDR-1) and human cytochrome P450 3A (CYP3A4 and CYP3A5) genes were analyzed and compared between steroid sensitive, steroid resistant and control groups. PMID: 30143489
- this meta-analysis suggests that the CYP3A4*1B polymorphism might play a modest role in susceptibility to cancer, especially for leukemia. PMID: 30143500
- JNK is a novel mechanistic regulator of CYP3A4 induction by PXR. PMID: 29440179
- The other four metabolites were almost exclusively metabolized by CYP3A4. PMID: 29475834
- It observed an increase in the activity of CYP3A following but not during pregnancy when measured using the 4beta-hydroxycholesterol/cholesterol ratio. In addition, based on our results, it suggestes that the plasma 4beta-hydroxycholesterol/cholesterol ratio be used to measure CYP3A activity in pregnant women. PMID: 29759884
- These findings also suggest that EGF may be an important regulator of CYP3A4 expression in vivo. PMID: 29189189
- our results indicate that a significant level of MDR1 mRNA, but not CYP3A4 mRNA, is intrinsically present before chemotherapy in advanced STS tumors. PMID: 29689707
- A weak-to-moderate CYP3A4 induction by midostaurin. PMID: 29117990
- CYP3A4 *18B and GCK G-30A polymorphisms were related to new-onset diabetes after transplantation (p < 0.05). The lower concentration/dose or fasting serum glucose was in CYP3A4 *1/*1 carriers than that in *18B/*18B carriers in all the renal transplant recipients (p < 0.05), respectively. PMID: 29546446
- Data suggest high similarity in mechanisms involved in regulation of expression of pig CYP3A29 and human CYP3A4 in hepatocytes. PMID: 30153482
- rs7668282 (UGT2B7, T>C) was more prevalent in sodium valproate (VPA)-resistant patients than drug-responsive patients. rs2242480 (CYP3A4, C>T) and rs10188577 (SCN1A, T>C) were more prevalent in drug-responsive patients compared to drug-resistant patients. In children with generalized seizures on VPA therapy, polymorphisms of UGT2B7, CYP3A4, and SCN1A genes were associated with seizure reduction. PMID: 29679912
- There were no significant differences in the bosutinib C0 between genotypes for ABCB1, ABCG2, and CYP3A4 polymorphisms. PMID: 29736778
- These results suggest that human and marmoset P450 3A4/90 and 4F12 in livers or small intestines played important roles in terfenadine t-butyl hydroxylation. Marmosets could be a model for humans during first pass extraction of terfenadine and related substrates. PMID: 28436281
- This first description of CYP3A4*20 null genotype in liver-transplanted patients, supports the relevance of CYP3A genotyping in tacrolimus therapy PMID: 29256966
- We demonstrate for the first time that the effect of ABCB1 diplotype on tacrolimus disposition is dependent on both CYP3A5 and CYP3A4 genotype. PMID: 27378609
- Some flavonoids exhibit selective inhibition toward CYP3A4 rather than other major cytochromes. Here, data suggest high risk of herb-drug interactions or food-drug interactions could be caused by flavonoids; vital structural elements of natural flavonoids could lead to interactions with clinical drugs normally eliminated via CYP3A4 metabolism. PMID: 29753067
- The mAb concomitantly shifted IL-1beta IC50 values towards CYP3A4 activity. PMID: 28260174
- CYP3A4 was identified as a novel tumor suppressor gene related to a poor prognosis in HCC. PMID: 29109094
- In CYP3A4, the most energetically favorable docking mode places testosterone in a position with the methyl groups directed toward the heme iron PMID: 28986474
- this study indicates that CYP3A activity is regained subsequent to kidney transplantation PMID: 28928137
- Younger age, POR*28 allele, and CYP3A5*3 allele were associated with higher cyclosporine dosing requirements and lower concentration/dose ratio. PMID: 29135906
- Single nucleotide polymorphism rs4646437 in CYP3A4 at 7q21.1 (p = .0325), associated with alpha-adrenergic receptor antagonist drug effect in Benign Prostatic Hyperplasia. PMID: 28787260
- CYP3A4*1B is associated with CsA C0/Dose ratio in renal transplant recipients which indicates patients with CYP3A4*1B allele require lower dose of CsA to reach target blood concentration compared with the CYP3A4*1 carriers.[meta-analysis] PMID: 29678659
- The MDR1/CYP3A4/OPRM1 gene polymorphisms influenced the fentanyl consumption and the physiological effects of intravenous analgesia in the Chinese women who received lower segment caesarean section surgeries. PMID: 29601950
- Molecular dynamics simulations reveal significantly different modes of interactions of DND and ARVL with the substrate binding pocket and with a peripheral allosteric site. Interactions of both substrates with residues F213 and F219 at the allosteric site play a critical role in the communication of conformational changes induced by effector binding to productive binding of the substrate at the catalytic site. PMID: 29200287
- The results of this study suggested that the Prospective assaying of CYP3A-status (CYP3A4 expression, CYP3A5 genotype) may better identify the Alzheimer patients with higher risk of inefficiency or adverse reactions and may facilitate the improvement of personalized clozapine therapy PMID: 28340122
- In oral contraceptive users, haplotype A and B in the CYP3A4 gene were associated with venous thrombosis risk, but not in non-users; however, the effect on Sex-hormone-binding-globulin levels was not directional with the risk. PMID: 28579309
- The combined CYP3A4 and CYP3A5 genotype of renal transplant recipients has a major influence on the Tacrolimus dose required to reach the target exposure. PMID: 28704257
- We solved the 2.7 A crystal structure of the CYP3A4-midazolam (MDZ) complex, where the drug is well defined and oriented suitably for hydroxylation of the C1 atom, the major site of metabolism. This binding mode requires H-bonding to Ser119 and a dramatic conformational switch in the F-G fragment, which transmits to the adjacent helices, resulting in a collapse of the active site cavity and MDZ immobilization. PMID: 28031486
- Our results provide information on CYP3A4 polymorphisms in Tibetan individuals which may help to optimize pharmacotherapy effectiveness by providing personalized medicine to this ethnic group. PMID: 28674221
- Among two SNPs in CYP3A4 and CYP3A5 and 12 SNPs in ABCB1 gene, an association with ovarian cancer risk was observed for ABCB1 rs2157926 SNP only. PMID: 29491071
- Low CYP3A4 Activity is associated with Crohn's Disease. PMID: 28301431
- Cryopreserved human hepatocytes can be stored stably for more than a decade with little or no change in CYP3A4/5 induction. PMID: 28411281
- Associations between SLCO1B1 521C and cholesterol response were not detected in African Americans (n = 333). Associations between CYP3A4*22 or CYP3A5*3 and cholesterol response were not detected in whites or African Americans. PMID: 28482130
- This kdeg value for CYP3A4 was in good agreement with recently reported values. PMID: 28289057
- Sorafenib was poorly tolerated, and anti-Kaposi sarcoma (KS)activity was modest. Strong CYP3A4 inhibitors may contribute to sorafenib toxicity, and ritonavir has previously been shown to be a CYP3A4 inhibitor. Alternate antiretroviral agents without predicted interactions should be used when possible for concurrent administration with sorafenib PMID: 28341759
- A total of 84.8% of our patients were found to express both the CYP3capital A, Cyrillic5*3*3 genotype and CYP3capital A, Cyrillic4*1*1/*1*1B. Further studies are necessary in order to show the influence of these genetic polymorphisms on tacrolimus blood concentrations. PMID: 29314799
- This study has identified 4 synonymous variants in the HCN4 gene and 3 SNPs in the CYP3A4 gene. None of the variants appear to have a major effect on the reduction of HR produced by ivabradine. PMID: 27439367
- Methylation status of cytosine in the CYP3A4 proximal promoter correlated with changes in developmental expression of mRNA. PMID: 26772622
- Occupancy by modified histones was consistent with chromatin structural changes contributing to the mechanisms regulating CYP3A4 ontogeny. PMID: 26921389
- Hydroxyl metabolite (M3) of VX-509 which is formed via the aldehyde oxidase pathway is responsible for CYP3A4 inhibition. PMID: 27298338
- CYP3A5 genotype has minimal impact on the probability of quetiapine target attainment of the 1-hour concentrations but a significant impact on the 12-hour concentrations. PMID: 27137148
- CYP3A4 expression and N-acetyl transferase 2 acetylator phenotype can better identify the patients with higher risk of adverse reactions and can facilitate the improvement of personalized clonazepam therapy and withdrawal regimen. PMID: 27639091
- The dose-dependent FaFg of selective and dual CYP3A and/or P-gp substrates was well predicted. PMID: 27538919
- The magnitude of drug-drug interactions (DDIs) for studies with rifampicin and seven CYP3A4 probe substrates. PMID: 27026679
- This finding equated to lower cytochrome P450 isoform 3A4 (CYP3A4) EC50 values in the HepatoPac system. PMID: 27655038
顯示更多
收起更多
-
亞細胞定位:Endoplasmic reticulum membrane; Single-pass membrane protein. Microsome membrane; Single-pass membrane protein.
-
蛋白家族:Cytochrome P450 family
-
組織特異性:Expressed in prostate and liver. According to some authors, it is not expressed in brain. According to others, weak levels of expression are measured in some brain locations. Also expressed in epithelium of the small intestine and large intestine, bile du
-
數據庫鏈接:
Most popular with customers
-
-
YWHAB Recombinant Monoclonal Antibody
Applications: ELISA, WB, IHC, IF, FC
Species Reactivity: Human, Mouse, Rat
-
Phospho-YAP1 (S127) Recombinant Monoclonal Antibody
Applications: ELISA, WB, IHC
Species Reactivity: Human
-
-
-
-
-